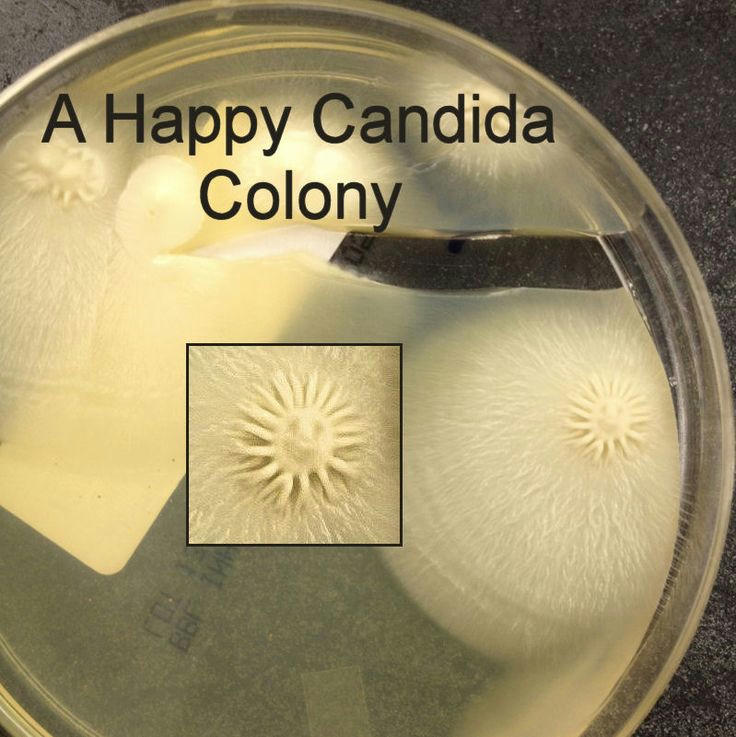

+ نوشته شده در دوشنبه ۱۳۹۲/۰۶/۲۵ساعت 14:18 توسط امیر
|
علوم آزمایشگاهی | Lab sciences
علوم آزمایشگاهی ، مطالب آزمایشگاهی ، معرفی تکنیک ها و روشهای آزمایشگاهی برای شناسایی بیماری هاو ...

تعداد مطالب وبلاگ: بیش از 570
این وبلاگ حاصل تجربیات هر چند اندک بنده و دوستان است . سعی میکنیم که از ای بوکها و مطالب به روز اطلاعات خودمون را دریافت کنيم و بیشتر مطالب وبلاگ هم حاصل ترجمه همین مطالب خواهد بود.
خوشحال می شويم اگر دوستان آزمایشگاهی هم به ما در این راه ، کمک کنند و با هم فکری دیگر ، وبلاگ به روز و به درد به خوری را داشته باشیم تا علاوه بر کسب تجربه سایر دوستان،قدم ناچیزی هم در اشاعه رشته زیبای خود در بین عموم مردم داشته باشیم.
در ضمن منتظر نظرات شما هستیم و سعي مي شودکه در همان روز جواب نظرات شما داده شود . بعدا اینکه این وبلاگ تقريبا هر روز آپدیت می شود و مطمئن باشید که هیچ یک از مطالب وبلاگ کپی برداری نیست و وبلاگ جامع علوم آزمايشگاهي اولین محل انتشار آنها است .
ازتون خواهشی داریم .... اگر مطالب وبلاگ را کپی می کنید هیچ گونه مشکلی نیست اما فقط منبع را ذکر کنید تا ساعت ها کار دوستان و خودم بیهوده و بی ارزش نباشد.
کانال تلگرام ما
برگه اول
رایانامه
بایگانی وبلاگ
عناوین مطالب وبلاگ
خوراک وبلاگ- RSS
آخرین مطالب
نویسندگان
امیرزهرا(علوم ازمایشگاهی تهران)
داوود رجبیان( علوم آزمایشگاهی یزد)
خراسانی(علوم ازمایشگاهی تهران)
احسان (علوم پزشکی همدان)
نوشته های قبلی(از مرداد 1388)
آبان ۱۴۰۲خرداد ۱۴۰۲
فروردین ۱۴۰۰
مرداد ۱۳۹۹
فروردین ۱۳۹۶
مهر ۱۳۹۵
شهریور ۱۳۹۵
مرداد ۱۳۹۵
آذر ۱۳۹۴
بهمن ۱۳۹۲
دی ۱۳۹۲
آذر ۱۳۹۲
مهر ۱۳۹۲
شهریور ۱۳۹۲
مرداد ۱۳۹۲
تیر ۱۳۹۲
خرداد ۱۳۹۲
فروردین ۱۳۹۲
اسفند ۱۳۹۱
بهمن ۱۳۹۱
دی ۱۳۹۱
آذر ۱۳۹۱
آبان ۱۳۹۱
مهر ۱۳۹۱
شهریور ۱۳۹۱
مرداد ۱۳۹۱
تیر ۱۳۹۱
خرداد ۱۳۹۱
اردیبهشت ۱۳۹۱
فروردین ۱۳۹۱
اسفند ۱۳۹۰
بهمن ۱۳۹۰
دی ۱۳۹۰
آذر ۱۳۹۰
آبان ۱۳۹۰
مهر ۱۳۹۰
آرشيو
آرشیو موضوعی
ژنتیکعکس
وبلاگ
بیوشیمی
بانک خون
مناسبت ها
هورمون شناسی
سایر مباحث
سوال و جواب
نمونه گیری
خون شناسی
قارچ شناسی
بافت شناسی
انگل شناسی
ویروس شناسی
ایمنی شناسی
باکتری شناسی
اخبار آزمایشگاهی
علوم ازمایشگاهی
ایمنی در آزمایشگاه
انگلیسی | English
کارشناسی به ارشد
کاردانی به کارشناسی
تاریخچه علوم آزمایشگاهی
دانلود(ایبوک، نرم افزار و عکس)
تشخیص آزمایشگاهی
منابع برخط و اینترنتی
دستگاه های آزمایشگاهی
پیوندها
انجمن علمی دکترای علوم آزمایشگاهیدوستان آزمایشگاهی
دانشجویان علوم ازمایشگاهی علوم پزشکی ارومیه
میکروبیولوژی فسا
انجمن هماتولوژی دانشجویان علوم آزمایشگاهی ایران
مدیریت کیفیت در مرازک آزمایشگاهی